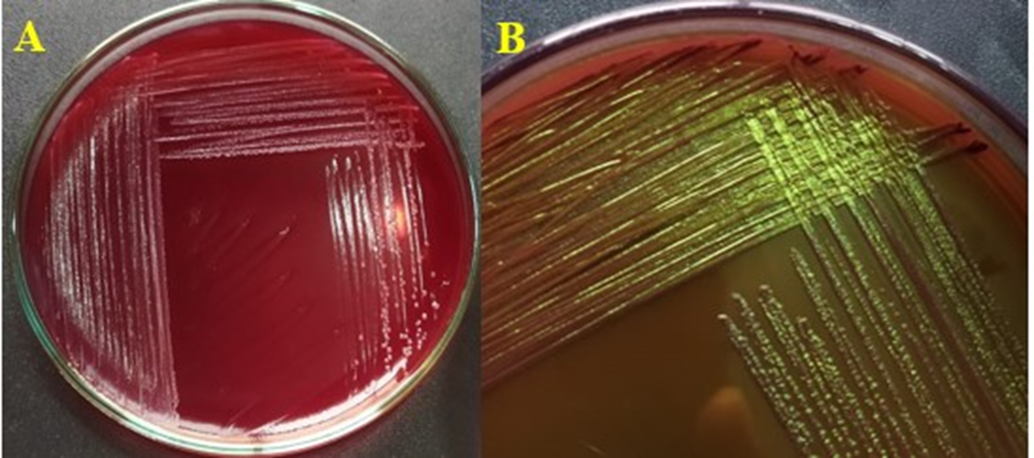

Abstract
Street vended fruit juices are widely consumed in Pakistan, particularly during extreme summer heat, providing essential nutrition values mostly fulfilled by fruits and their juices. Generally, microbial growth in juice is restricted by using preservatives and storage temperatures. From public health point of view, presence of microbes can cause foodborne diseases and outbreaks. This study assess microbial quality of fresh Grewia asiatica (falsa) juice samples collected from street vendors near UCP, Lahore. Analysis of 25 samples revealed that 75% exceeded permissible microbial limits for unpasteurized beverages, with TVC ranging from 1.2×102 to 3.2×104 CFU/mL. Majority of isolates were identified as E. coli indicating fecal contamination likely due to unsafe water, poor hygiene, and contaminated ice used in juice preparation. This contamination poses risks for possible enteric infections and food born outbreaks particularly in peak of summer heat where demand is extremely high.
Keywords
Bacterial identifications, Biochemical test, E. coli, Food quality, Fruit juices, Falsa, Grewia asiatica
Introduction
temperatures routinely exceed 40°C, dehydration becomes a critical public health concern [1]. During these scorching conditions, urban populations increasingly turn to street vendors for immediate relief through readily available refreshing beverages. These street-vended drinks commonly include fresh fruit juices such as sugarcane juice, watermelon juice, falsa juice, mango juice, and various citrus-based beverages, which are perceived as natural remedies for heat-related stress and dehydration [2]. The recent record-breaking heatwaves in Pakistan have intensified this reliance on street beverages, with increased cases of heat-related illnesses driving consumers to seek quick hydration solutions from easily accessible vendors [3]. However, the urgent need for hydration often overrides food safety considerations, creating a dangerous intersection between public health necessity and microbiological risk, particularly when hygiene standards are compromised in informal food preparation settings [2].
While fruit juices are widely regarded as nutritious beverages that rich in essential vitamins, minerals, and dietary fiber. They can also serve as vehicles for microbial contamination if proper hygiene is not maintained throughout the supply chain. The surfaces of fruits may harbor a variety of bacterial and fungal pathogens, which can be introduced during pre-harvest activities such as irrigation with contaminated water, or post-harvest processes including handling, transportation, and storage. If these fruits are not thoroughly washed and sanitized before juice extraction, harmful microorganisms can persist and multiply in the final product [4]. Consumption of such contaminated juices has been linked to a spectrum of health issues, ranging from mild gastrointestinal disturbances like diarrhea to more severe infections such as pneumonia, meningitis, and even systemic illnesses, particularly in vulnerable populations such as children, the elderly, and immunocompromised individuals.
Since the human food supply consists basically of plants and animals or products derived from them, it is understandable that our food supply can contain microorganisms in interaction with the foods. When the microorganisms involved are pathogenic, like Escherichia coli, Salmonella species, Shigella species, and Staphylococcus aureus, they can lead to outbreaks of food poisoning and serious complications in vulnerable populations such as pregnant women, infants, and the elderly [5]. Freshly extracted fruit juices, which have always been considered as healthful drink, may not always be safe owing to the heavy load of microbes. The acidic nature of fruit juices does not consistently prevent pathogen survival, contrary to widespread assumptions, as studies have demonstrated that various pathogenic organisms can maintain viability in acidic environments for extended periods [6].
Grewia asiatica, commonly called falsa, remains a popular seasonal beverage in Pakistan due to its perceived health benefits and refreshing properties. It is valued for its rich antioxidant content and cooling properties [7]. This small, tangy fruit, which thrives in tropical and subtropical regions from May to July, has become a significant component of Pakistan's street food culture, with vendors throughout urban areas offering freshly prepared juice to meet the high demand during the intense summer heat. However, the fruit's high moisture content and neutral pH create ideal conditions for microbial proliferation when handled under unhygienic conditions [8]. Similarly, the intrinsic nature of fresh fruit juices, containing high water content and natural sugars, are also ideal for microbial proliferation in such circumstances [9].
Recent epidemiological data from the Punjab Food Authority reveals that 62% of foodborne illness outbreaks in Lahore originate from contaminated street beverages [10]. Escherichia coli serves as a critical indicator organism for fecal contamination, with pathogenic strains causing problems ranging from mild food poisoning to severe gastroenteritis through production of heat-stable enterotoxins. Although E. coli is mostly present in our intestines but some strains of E. coli are pathogenic in nature including Entero-toxigenic and Entero-pathogenic strains. The O157:H7 serotype alone accounts for approximately 2 million annual cases of hemorrhagic colitis in South Asia [11]. For the rationale of microbial surveillance current food safety protocols lack enforcement mechanisms for mobile vendors, creating potential reservoirs for enteric pathogens.
Fresh fruit juices are highly perishable due to their rich nutrient content and high water activity. When short-term storage is necessary, immediate application of basic preservation techniques is essential to maintain safety, nutritional value, and sensory qualities such as flavor, color, and aroma. The most common method among street food vendors include refrigeration at ≤4°C. It slows microbial activity and enzymatic degradation, extending freshness for a few days. Pasteurization (typically 60–90°C for a short time) and sterilization (higher temperatures for longer durations) are highly uncommon in urban street food culture of Pakistan.
The major ingredients of the juice such as water, sugar, natural fruit pulp etc. may also carry some microbial contaminants. Food-borne illness is commonly caused by certain bacteria or their toxins, which are poisonous proteins produced by these bacteria. The most common food borne pathogenic bacteria are Bacillus cereus, Clostridium botulinum, Escherichia coli, Shigella spp., Salmonella spp., Vibrio parahaemolyticus, Staphylococcusaureus, Campylobacter jejuni, Streptococcus pyogenes, Mycobacterium bovis, Listeria monocytogenes etc. (see Table 1). In pregnant women, the fetus is most heavily infected, leading to spontaneous abortion, stillbirths, or sepsis in infancy [12].
|
Parameter |
Total viable count |
Fecal coliform |
Coliform |
|
Maximum count anticipated |
5.0×103 |
0 |
10 |
|
Maximum count permitted |
1.0×104 |
0 |
100 |
Given the significant public health implications of microbial contamination in fresh fruit juices and the particular vulnerabilities of Pakistan's street food sector, this study aims identify major bacterial contamination in fresh Grewia asiatica juice collected from local vendors in Lahore, Pakistan. This assess the microbial load and the presence of pathogenic bacteria in this popular beverage.
Materials and Methods
Sample collection and preparation
Juice samples (n=25) were collected aseptically from vendors operating within 10 km radius of the University of Central Punjab campus. Vendors were selected through stratified random sampling to represent different preparation methods: 40% used municipal tap water, 35% utilized groundwater sources and 25% incorporated ice of unknown purity (see Table 2). Basic observation of environmental and hygiene conditions were made.
|
Fruit juice |
Collection area |
Sample code |
|
Grewia asiatica (falsa) |
Outside UCP, Johar Town Lahore |
M1 |
|
Grewia asiatica (falsa) |
Outside UCP, Johar Town Lahore |
M2 |
|
Grewia asiatica (falsa) |
Outside UCP, Johar Town Lahore |
M3 |
|
Grewia asiatica (falsa) |
Outside UCP, Johar Town Lahore |
M4 |
|
Grewia asiatica (falsa) |
Outside UCP, Johar Town Lahore |
M5 |
|
Grewia asiatica (falsa) |
Outside UCP, Johar Town Lahore |
M6 |
|
Grewia asiatica (falsa) |
Outside UCP, Johar Town Lahore |
M7 |
|
Grewia asiatica (falsa) |
Outside UCP, Johar Town Lahore |
M8 |
|
Grewia asiatica (falsa) |
Outside UCP, Johar Town Lahore |
M9 |
|
Grewia asiatica (falsa) |
Outside UCP, Johar Town Lahore |
M10 |
|
Grewia asiatica (falsa) |
Outside UCP, Johar Town Lahore |
G1 |
|
Grewia asiatica (falsa) |
Outside UCP, Johar Town Lahore |
G2 |
|
Grewia asiatica (falsa) |
Outside UCP, Johar Town Lahore |
G3 |
|
Grewia asiatica (falsa) |
Outside UCP, Johar Town Lahore |
G4 |
|
Grewia asiatica (falsa) |
Outside UCP, Johar Town Lahore |
G5 |
|
Grewia asiatica (falsa) |
Outside UCP, Johar Town Lahore |
G6 |
|
Grewia asiatica (falsa) |
Outside UCP, Johar Town Lahore |
G7 |
|
Grewia asiatica (falsa) |
Outside UCP, Johar Town Lahore |
G8 |
|
Grewia asiatica (falsa) |
Outside UCP, Johar Town Lahore |
G9 |
|
Grewia asiatica (falsa) |
Outside UCP, Johar Town Lahore |
I1 |
|
Grewia asiatica (falsa) |
Outside UCP, Johar Town Lahore |
I2 |
|
Grewia asiatica (falsa) |
Outside UCP, Johar Town Lahore |
I3 |
|
Grewia asiatica (falsa) |
Outside UCP, Johar Town Lahore |
I4 |
|
Grewia asiatica (falsa) |
Outside UCP, Johar Town Lahore |
I5 |
|
Grewia asiatica (falsa) |
Outside UCP, Johar Town Lahore |
I6 |
Samples were transported in sterile conical tubes (Falcon™ 50 mL) at 4°C and processed within 2 hours of collection. Particulate matter (pulp) was removed through sterile filtration (Whatman™ Grade 1, 11 μm pore size) prior to microbiological analysis as shown in Figure 1.

Figure 1. Step-wise workflow of falsa juice preparation, collection, and laboratory analysis.
Microbiological cultivation techniques
Aliquots (100 μL) were spread on Nutrient Agar (NA) using the spread plate method. Plates were incubated aerobically at 37°C for 24 hours (Memmert IN75). Representative colonies were subcultured on MacConkey Agar (MA) to differentiate lactose-fermenting enterobacteria using quadrant streak method. Plates were again incubated aerobically at 37°C for 24–48 hours (Memmert IN75). Confirmation was done by culturing the isolates on Eosin Methylene Blue (EMB) agar.
Microscopic characterization
Gram staining was performed using standard protocols using Crystal Violet (for 1 min) and Gram's iodine mordant (for 1 min) followed by decolorization by Ethanol for 30 sec and counter staining by Safranin counterstain (for 1 min). Slides were visualized under oil immersion (100×, Nikon Eclipse E200).
Biochemical confirmation
Presumptive E. coli colonies underwent biochemical confirmation through: Catalase Test using 3% H2O2 solution (Sigma-Aldrich 323381) followed by Oxidase Test using Tetramethyl-p-phenylenediamine strips (BD BBL 261081) and Indole Production Tryptophan broth (TB) with Kovac's reagent. Citrate Utilization was then performed using Simmons Citrate Agar (SCA).
Data analysis
Morphological characteristics were documented using standardized bacteriological descriptors. Biochemical profiles were compared against Bergey's Manual of Systematic Bacteriology criteria for Enterobacteriaceae identification.
Results
Sample collection
During sample collection, basic observations of vendor safeguarding measures were noted informally. None of the vendors used gloves, hairnets, hand sanitizers or disinfectants to clean their equipment. In all the cases, ice was stored in open containers and juicing equipment like blenders were rinsed with untreated tap or bucket water between customers. Above all refrigeration of ingredients particularly fruit was absent. Ice blocks were visibly exposed to the environment and often kept in open containers without protective covering. All vendors included in this study were male street sellers aged 20–50 years, operating small-scale roadside stalls outside UCP, Lahore. No formal training in food handling or hygiene was reported by any vendor.
Microbial load quantification
After incubation, the total number of colonies on each plate were counted. Initial plating revealed substantial microbial contamination across all samples (see Table 3). Total viable counts ranged from 1.2×102 to 3.2×104 CFU/mL, exceeding WHO permissible limits (<10² CFU/mL) for unpasteurized beverages. The highest average count was found as 3.2×104 cfu/ml in ice added fresh juices. This was followed by 2.8×103 cfu/ml in fresh juices that used ground water, as the second highest bacterial load. While lowest bacterial load of an average 1.2×102 cfu/ml was found in fresh juices that utilized municipal water.
|
Vendor Type |
Average CFU/Ml |
E. coli Prevalence |
|
Municipal Water |
1.2×102 |
64% |
|
Ice-Added |
3.2×104 |
88% |
|
Ground Water |
2.8×103 |
71% |
Morphological characterization
Presumptive E. coli isolates (M2, M3, M7, M9, M10, G2, G3, G4, G5, G7, G9, I1, I2, I3, I4, I5, I6) exhibited characteristic features on selective media. On Nutrient Agar circular, convex colonies (2–3 mm diameter) with entire margins were observed. These suspected colonies (from sample M1, M2, M3, M5, M7, M8, M9, M10, G1, G2, G3, G4, G5, G7, G9, I1, I2, I3, I4, I5, I6) were cultured on fresh agar for further detection and confirmation. On MacConkey agar pink lactose-fermenting round, raised and sticky colonies with precipitated bile salts were observed for E. coli. Whereas M1, M5, M8, G1 showed no growth on further inspection on MacConkey agar indication possible gram positive bacteria. All those lactose fermenting colonies were cultured on selective agar for confirmation of E. coli. For this purpose EMB agar was used. On EMB agar, colonies displayed a characteristic green metallic sheen, confirming the presence of E. coli (Figure 2). Only these samples were marked as possibly containing fecal contamination due to the presence of fecal coliform like E. coli.
Figure 2. a) Lactose-fermenting colonies on MacConkey Agar showing typical E. coli morphology, b) Green metallic sheen on EMB agar.
Microscopic characterization
Microscopic examination of lactose fermenting colonies isolated from the MacConkey agar plate (M2, M3, M7, M9, M10, G2, G3, G4, G5, G7, G9, I1, I2, I3, I4, I5, I6) revealed rod shaped, pink colored bacteria, as depicted in Figure 3. The pink coloration indicates presence of gram-negative bacteria, while the rod-shaped morphology are a characteristic feature of E. coli. These observations supported the preliminary identification. However, to conclusively confirm the presence of E. coli, further confirmatory biochemical tests were planned, including catalase, oxidase, indole, and citrate utilization assays. Whereas isolates M1, M4, M5, M6, M8, G1, G6, G8, G9 all showed rod shaped, purple colored bacteria (possibly gram-positive, non-pathogenic bacteria found in fresh juices including Alicyclobacillus species or certain lactic acid bacteria like Lactobacillus.

Figure 3. Gram-negative rods observed under oil imme rsion (1000× magnification).
Biochemical profiling
Most of the isolates (M2, M3, M7, M9, M10, G2, G3, G4, G5, G7, G9, I1, I2, I3, I4, I5, I6) demonstrated biochemical profiles consistent with E. coli (see Table 4). These samples were also the ones that showed characteristics metallic green sheen on EMB agar indicating E.coli. Following Bergey’s manual oxidase test was performed to separate Enterobacteriaceae from other gram negative bacilli. Sample M2, M3, M7, M9, M10, G2, G3, G4, G5, G7, G9, I1, I2, I3, I4, I5, I6 showed negative oxidase result as no color change was observed. Thus these were further tested for catalase test following the manual. Positive catalase aligns with the biochemical profile of E. coli. The indole-positive, citrate-negative pattern excluded other Enterobacteriaceae members like Klebsiella pneumonia.
|
Sample code |
Gram Stain |
Catalase (Bubble formation) |
Oxidase (color change) |
Indole Production (Red ring formation) |
Citrate Utilization (color change) |
Presences of fecal coliform |
|
M1 |
+ |
- |
- |
- |
- |
Not detected |
|
M2 |
- |
+ |
- |
+ |
- |
E.coli |
|
M3 |
- |
+ |
- |
+ |
- |
E.coli |
|
M4 |
- |
+ |
+ |
+ |
- |
Not detected |
|
M5 |
- |
- |
- |
- |
- |
Not detected |
|
M6 |
+ |
- |
- |
- |
- |
Not detected |
|
M7 |
- |
+ |
- |
+ |
- |
E.coli |
|
M8 |
+ |
- |
- |
- |
+ |
Not detected |
|
M9 |
- |
+ |
- |
+ |
- |
E.coli |
|
M10 |
- |
+ |
- |
+ |
- |
E.coli |
|
G1 |
+ |
- |
- |
- |
- |
Not detected |
|
G2 |
- |
+ |
- |
+ |
- |
E.coli |
|
G3 |
- |
+ |
- |
+ |
- |
E.coli |
|
G4 |
- |
+ |
- |
+ |
- |
E.coli |
|
G5 |
- |
+ |
- |
+ |
- |
E.coli |
|
G6 |
+ |
+ |
- |
+ |
- |
Not detected |
|
G7 |
- |
+ |
- |
+ |
- |
E.coli |
|
G8 |
+ |
- |
+ |
+ |
+ |
Not detected |
|
G9 |
- |
+ |
- |
+ |
- |
E.coli |
|
I1 |
- |
+ |
- |
+ |
- |
E.coli |
|
I2 |
- |
+ |
- |
+ |
- |
E.coli |
|
I3 |
- |
+ |
- |
+ |
- |
E.coli |
|
I4 |
- |
+ |
- |
+ |
- |
E.coli |
|
I5 |
- |
+ |
- |
+ |
- |
E.coli |
|
I6 |
- |
+ |
- |
+ |
- |
E.coli |
|
NOTE: +: positive; -: negative |
||||||
Discussion
Fruit juices are widely consumed beverages across all age groups worldwide due to their palatability, nutritional content, and perceived health benefits. In recent years, the demand for freshly prepared fruit juices has seen a notable increase in Pakistan [13], where they are often preferred over carbonated soft drinks. Their popularity is largely attributed to improved taste, convenience in handling, and accessibility, which may vary depending on processing techniques and storage conditions [13]. Despite these advantages, fruit juices are highly perishable products that can support the growth of a variety of microorganisms. Due to their high sugar content, low pH (typically between 3.0 and 4.5), and the presence of nutrients such as vitamins and organic acids, juices provide an ideal environment for the growth of yeasts, molds, and acid-tolerant bacteria [14]. While many of these microorganisms are non-pathogenic, including saprophytic bacteria and wild-type yeasts (Saccharomyces spp., Candida spp.), some may contribute to spoilage, resulting in off-flavors, gas formation, and turbidity [15]. More concerning, however, is the potential contamination by pathogenic species such as Escherichia coli, Salmonella spp., and Listeria monocytogenes, which can pose serious public health risks [16]. Microbial contamination can occur at multiple stages. By detecting the initial bacterial load in the juice, it apparently gives an idea about the quality of the sample. Therefore, aerobic plate count or total counts of the juice samples were carried out in this experiment.
The viable bacterial count observed in most of the fresh juice samples was higher than maximum permitted levels established by international standards. The highest count was found as 3.2×104 cfu/ml in ice, 2.8×103 cfu/ml in ground water and 1.2×102 cfu/ml in municipal water added fresh juice respectively. Though most of the juice samples showed equal or slightly higher count than the permitted count. These were still unfavorable for consumption because sixteen of them showed the presence of coliform. The presence of coliform in fruit juice is not allowed by safe food consumption standard [17]. Coliform was identified as E. coli, which can produce many systematic infections after consumption.
However, while culture-based and biochemical methods are cost-effective and accessible, they may lack the specificity and sensitivity of molecular techniques. For instance, PCR amplification targeting the uidA gene or other E. coli-specific markers can provide rapid and definitive identification, as demonstrated by A. A. Ogunjimi and P. V. Choudary [18], who reported increased detection rates of pathogenic strains in fruit juices using molecular assays. Incorporating such techniques in future studies would enhance diagnostic accuracy and allow for the identification of virulent or antibiotic-resistant E. coli strains, which are of particular concern in the context of rising antimicrobial resistance.
All coliform detected samples were indicators of fecal contamination in 75% of tested samples, with viable Escherichia coli counts exceeding WHO recommended limits for ready-to-consume beverages. The findings highlight a public health concern and point to widespread lapses in hygiene practices among street vendors in Lahore. The most plausible sources of contamination include fecal-oral transmission through unwashed hands, the use of contaminated water for washing fruits or preparing juice, and cross-contamination during ice addition, each of which has been previously implicated in foodborne outbreaks in similar urban settings [19,20]. These findings are consistent with those reported by Bhat and Waghray [21], who documented E. coli prevalence rates ranging from 72% to 89% in street-vended beverages across South Asia.
Studies have documented that only 29.1% of street food vendors consistently wash their hands before handling food, despite 87.8% cleaning utensils with soap and water [22]. Common practices included wearing aprons (79.1%) and head caps (86.6%), but knowledge of using masks (33.9%) and gloves (41.7%) to prevent food contamination was limited. Environmental hygiene was inadequate, with 61.0% of vendors reporting pest presence near vending sites [22]. This inconsistency in hygiene practices creates opportunities for direct contamination of beverages through manual handling. Research from Southeast Asia reveals that 94.4% of street food vendors wash their utensils with bucket water from restrooms, which is not sterile and becomes a significant source of microbial contamination. The repetitive use of the same water throughout the day for cleaning purposes results in cross-contamination, with 91% of dishwater, 65% drinking water and 100% ice cubes samples showing fecal contamination in studies from Jakarta [23].
The juices that are mishandled and mistreated during preparation or storage generally cause most outbreaks. The observation that ice-added samples exhibited higher contamination rates aligns with the study conducted by Atter et al. [24], who attributed elevated microbial loads in street drinks to the use of non-potable water in ice production and inadequate ice handling. The high prevalence of E. coli in this study reflects systemic hygiene failures. Similar methodologies have been successfully employed in previous studies investigating street food contamination in Pakistan and India [13,25]. Studies from major brazil cities found that over 75% of ice samples from street vendors contained high microbial loads unsafe for health, with significant presence of coliform bacteria and other pathogenic microorganisms [26].
Because all samples were collected during the peak summer months of June and July, when average temperatures in Lahore regularly exceed 40°C, microbial proliferation is expected to be higher compared to cooler seasons. Seasonal temperature variations are known to influence microbial growth, survival and replication in beverages. Due to this, the contamination levels observed in this study represent the upper seasonal extremes of microbial load.
The informal data collection at start provided a rough but systematic study of vendor with safeguarding practices such as hand washing, cleaning, lack of refrigerated storage, disinfecting equipment and washing fruits. These simple observations indicated that gloves were not used and hand washing was evidently rare. Contaminated water was used for cleaning blenders and other equipment. The high contamination levels were probably due to these protective measures not being taken. These combined aspects contributed to the high microbial loads and high diarrheal outbreak level in these regions. According to the data provided in Table 3, direct analysis of the source contribution patterns can be done. This links contamination levels quantitatively to vendor type. As indicated by the mentioned dataset, ice-added juices showed the highest load. Following these points groundwater-based juices and juices prepared using municipal water showed comparatively lower contamination. This gradient suggests ice as the major contamination source among all possible points. This narrative supports the previous interpretation that ice, often manufactured using non-potable water and stored under unhygienic conditions, serves as the primary contamination source.
Lack of knowledge regarding hygienic practices, safe juice preparation methods, and potential contamination sources significantly contributes to microbial contamination in the fruit juice industry. Workers or Vendors involved in juice production often lack formal training in microbiological safety, leading to unintentional lapses in cleanliness and processing standards. Contamination may occur at various critical control points, including the improper washing of raw fruits, the use of unclean equipment, cross-contamination from handlers, and exposure to unsanitary environmental conditions. Such oversights can facilitate the proliferation of spoilage organisms and pathogenic microorganisms such as Salmonella spp., Escherichia coli, and Staphylococcus aureus. These pathogens may persist on fruit surfaces or processing tools and survive inadequate thermal treatments or poor storage practices, thus compromising both product safety and public health. It is essential that personnel involved in fruit juice handling and production receive comprehensive training in food hygiene and safe handling techniques. Good Manufacturing Practices (GMP), Hazard Analysis and Critical Control Points (HACCP), and routine microbiological monitoring are mostly implemented to reduce contamination risks and ensure the microbial safety of the final product in industrial sector. But such practices are not applicable in case of street vendors.
In contrast, studies from regions with stricter food safety regulations, such as Singapore and certain Middle Eastern countries, have reported substantially lower rates of E. coli contamination in street foods [27]. Singapore's food safety regulations maintain strict standards with E. coli limits of less than 100 colony forming units per gram for ready-to-eat foods [28]. Similarly, international standards such as those from Ireland specify that E. coli levels should remain below 20 cfu/g for acceptable quality and below 100 cfu/g for the threshold of unacceptable contamination [29]. In contrast, regions with less stringent enforcement report substantially higher contamination rates. Studies from Middle Eastern countries with stronger regulatory frameworks demonstrate lower E. coli contamination rates in street foods compared to South Asian markets [30]. The ASEAN Food Safety Network has been established to facilitate information exchange and harmonize standards across member countries, but implementation remains inconsistent. Bangladesh's regulatory framework through the Bangladesh Standards and Testing Institution (BSTI) includes provisions for monitoring food safety, with special drives targeting fruit drinks and syrups. However, the limited number of mandatory product standards means that most food businesses operate without certification, creating regulatory gaps in oversight.
Along with improving vendor hygiene and practices, consumer education is essential. Many consumers are unaware of the risks associated with ice-added or visibly unhygienic juice stalls. Most of them even consider it less of a health hazard and do not know the extent of outbreaks it is causing. Encouraging the public to avoid ice from unknown sources, prefer vendors who wash fruits and recognize signs of poor sanitation can significantly reduce exposure to foodborne pathogens. The E.coli isolates identified in this study were indicative of fecal contamination, and although serotyping was not performed, even non-O157 strains can cause gastrointestinal symptoms including diarrhea, abdominal cramps and vomiting. Fecal coliform contamination in beverages is strongly associated with enteric infections and ingestion of 10²–10³ CFU/mL levels detected in this study, has been linked to outbreaks in South Asian populations especially in these populated urban centers.
The microbiological safety of fresh fruit juices is a critical determinant of consumer safety and public health, particularly in developing countries like Pakistan where informal juice vending is widespread. Unlike processed and packaged juices, fresh fruit juices are often prepared and sold under unregulated conditions, frequently at roadside stalls, markets, or small-scale establishments. Negligence in maintaining sanitary conditions not only results in diminished product quality but also poses serious health risks to consumers, including foodborne illnesses and gastrointestinal infections. The root cause often lies in the lack of knowledge and awareness among juice vendors regarding basic food safety principles. Despite being preventable, these conditions persist due to limited access to food safety education, absence of regulatory enforcement, and poor public awareness.
The study also did not assess the role of packaging materials such as plastic cups, stainless steel blenders, and storage containers. These surfaces can serve as secondary contamination points if not properly sanitized. Previous studies report that biofilm formation inside juicing equipment or repeated use of unwashed plastic cups can contribute substantially to microbial load [31]. After collection, it was observed that all the vendors take almost none safeguarding measures to maintain the quality and safety of the juice. Most of the vendors (80%) immediately transferred freshly prepared juice to clean plastic but uncovered cups and handed them directly to the consumer. This risks exposure to dust, insects and even airborne microbes. None of the vendors stored any juice or ingredient in refrigeration or coolers at low temperatures to slow microbial growth. Only 18% of the vendors separated different juice batches to avoid cross-contamination and aim to sell the juice within a short period to reduce the risk of spoilage. Most of them (82%) were mixing all the batches and were even selling long term (approximately 30 minutes) premade juices.
To address this issue, it is essential that local authorities and national regulatory agencies such as the Pakistan Standards and Quality Control Authority (PSQCA), in collaboration with municipal health departments, initiate monitoring and microbiological surveillance of fresh fruit juice vendors. Implementation of WHO Food Safety Guidelines could reduce foodborne illness incidence by 40–60% within 2 years. Through public awareness and such initiatives, the microbial safety of fresh fruit juices in Pakistan can be significantly improved, reducing health risks and promoting consumer confidence.
Limitations and Future Prospect
The main purpose of this study was the monitoring and initial cause determination behind various factors contributing to the wide spread of outbreaks during heat wave season. Due to which many other aspects were not included. In this study we only collected our data during peak summer, averaging seasonal temperatures to 40-45°C. Due to this it does not account for the seasonal differences in vendor practices or microbial counts which could vary in winter or mild temperature climates. Although the study provides valuable perspective, the sample size (n=25) is relatively small and drawn from a single district. A larger dataset from multiple cities and diverse socioeconomic zones would increase statistical power and improve generalizability. The study also did not collect detailed demographic information (education level, training background, experience) from juice vendors. Lack of demographic diversity assessment limits the ability to correlate hygiene practices with vendor characteristics. All these points can be used to further research this aspect of seasonal outbreaks in population centered areas of cities.
Conclusion
The findings of this study align with earlier reports from Karachi, Dhaka, and New Delhi, where E.coli contamination in street-vended juices ranged between 60–90%. Similar to studies from Brazil and Ghana, the highest contamination levels were associated with ice-added beverages. The consistency of these patterns across different regions indicates the persistent public health challenge posed by unregulated juice vending.
Acknowledgements
Authors are thankful to the Faculty of Sciences and Technology, University of Central Punjab, Lahore for laboratory facility, and no potential conflicts of interest are noted.
Declarations
Funding
Not applicable. This research received no external funding. All research material was provided by Microbiology lab of the University of Central Punjab.
Conflicts of interest/competing interests
The authors declare that they have no known competing financial interests or personal relationships that could have appeared to influence the work reported in this paper.
Ethics approval
Not applicable. This study did not involve human participants or animal subjects.
Consent to participate
Not applicable.
Consent for publication
All authors read and approved the final manuscript for publication
Availability of data and material
The data supporting the findings of this study are available from the corresponding author upon reasonable request.
Code availability
Not applicable. No custom software or code was used in this study.
Authors' Contributions
SNF and SA conceptualized the study and design. SNF, SA, FA, IS performed data collection and analysis. SA performed data organization. Microbiological analysis was conducted by SNF, FA and SA. All authors contributed to data interpretation. The first draft of the manuscript was written by SNF. All authors reviewed and commented on previous versions. All authors read and approved the final manuscript.
References
2. Khan TN, Itrat M, Ansari TH. Public health approach of Unani medicine to cope and stay safe in hot environmental conditions. J Basic Clin Physiol Pharmacol. 2021 Mar 15;33(3):235–41.
3. Anwar NH, Khan HF, Abdullah A, Macktoom S, Fatima A. Heat governance in urban South Asia: The case of Karachi.2022.
4. Iwu CD, Okoh AI. Preharvest Transmission Routes of Fresh Produce Associated Bacterial Pathogens with Outbreak Potentials: A Review. Int J Environ Res Public Health. 2019 Nov 11;16(22):4407.
5. Asghar U, Nadeem M, Nelofer R, Mazhar S, Syed Q, Irfan M. Microbiological assessment of fresh juices vended in different areas of Lahore city. Electronic Journal of Biology. 2018;14(4):106–10.
6. Tenea GN, Reyes P, Molina D, Ortega C. Pathogenic Microorganisms Linked to Fresh Fruits and Juices Purchased at Low-Cost Markets in Ecuador, Potential Carriers of Antibiotic Resistance. Antibiotics (Basel). 2023 Jan 22;12(2):236.
7. Khan RS, Asghar W, Khalid N, Nazir W, Farooq M, Ahmed I, et al. Phalsa (Grewia asiatica L) fruit berry a promising functional food ingredient: A comprehensive review. J Berry Res. 2019 Jun 18;9(2):179–93.
8. Kaur S, Shams R, Dash KK, Pandey VK, Shaikh AM, Harsányi E, et al. Phytochemical and pharmacological characteristics of phalsa (Grewia asiatica L.): A comprehensive review. Heliyon. 2024 Jan 19;10(2):e25046.
9. Mengistu DA, Baraki N, Gobena Tesema T. Pathogenic Bacterial Species in Locally Prepared Fresh Fruit Juices Sold in Juice Houses of Eastern Ethiopia. Microbiol Insights. 2021 Dec 9;14:11786361211060736.
10. Ismail S, Ullah K, Sunnya H, Bingjie X. Overview of O157 in Pakistan: An Important Food-Borne Disease of Public Health. The journal of microbiology and molecular genetics. 2021 Dec 31;2(3):1–21.
11. Melebari M. Shiga Toxin-Producing Escherichia coli: A Focused Review of the Middle East Countries.
12. Smith JL. Foodborne infections during pregnancy. J Food Prot. 1999 Jul;62(7):818–29.
13. Alamgir A, Fatima N, Khan MA, Shaukat SS. Microbiological assessment of street vended fresh fruit juices available in the Karachi city. International Journal of Biology and Biotechnology. 2015;12(3):505–9.
14. Shankar V, Mahboob S, Al-Ghanim KA, Ahmed Z, Al-Mulhm N, Govindarajan M. A review on microbial degradation of drinks and infectious diseases: A perspective of human well-being and capabilities. J King Saud Univ Sci. 2021 Mar 1;33(2):101293.
15. Comitini F, Canonico L, Agarbati A, Ciani M. Biocontrol and Probiotic Function of Non-Saccharomyces Yeasts: New Insights in Agri-Food Industry. Microorganisms. 2023 May 30;11(6):1450.
16. Shahbaz HM, Kim JU, Kim SH, Park J. The Inactivation of pathogens in fruit juice: Escherichia coli O157: H7, Salmonella Typhimurium, and Listeria monocytogenes. InFruit juices 2018 Jan 1.pp. 341–61.
17. National Research Council, Committee to Ensure Safe Food from Production to Consumption. Ensuring Safe Food: From Production to Consumption. National Academies Press; 1998 Sep 19.
18. Ogunjimi AA, Choudary PV. Adsorption of endogenous polyphenols relieves the inhibition by fruit juices and fresh produce of immuno-PCR detection of Escherichia coli 0157: H7. FEMS Immunol Med Microbiol. 1999 Mar 1;23(3):213–20.
19. Were L, Were G, Aduol KO. Hygiene practices and microbial contamination of street-vended foods in Kenyatta University’s Environs. European Journal of Agriculture and Food Sciences. 2020 Oct 14;2(5).
20. Odeyemi OA. Public health implications of microbial food safety and foodborne diseases in developing countries. Food Nutr Res. 2016 Jan 1;60(1):29819.
21. Bhat RV, Waghray K. Profile of street foods sold in Asian countries. World Rev Nutr Diet. 2000 Jan 1;86:53–99.
22. Klutse CM, Sampson GO. Assessment of Hygiene Practices and Knowledge of Food Safety among Street Food Vendors in the Volta Region, Ghana. Eur J Nutr Food Saf. 2025 Jan 1;17(1):1–0.
23. Vollaard AM, Ali S, Van Asten HA, Ismid IS, Widjaja S, Visser LG, et al. Risk factors for transmission of foodborne illness in restaurants and street vendors in Jakarta, Indonesia. Epidemiology & Infection. 2004 Oct;132(5):86–72.
24. Atter A, Ofori H, Anyebuno GA, Amoo-Gyasi M, Amoa-Awua WK. Safety of a street vended traditional maize beverage, ice-kenkey, in Ghana. Food Control. 2015 Sep 1;55:200–5.
25. Tabashsum Z, Khalil I, Nazimuddin MD, Mollah AK, Inatsu Y, Bari ML. Prevalence of foodborne pathogens and spoilage microorganisms and their drug resistant status in different street foods of Dhaka city. Agriculture Food and Analytical Bacteriology. 2013 Dec;3(4):281–92.
26. Cortese RD, Veiros MB, Feldman C, Cavalli SB. Food safety and hygiene practices of vendors during the chain of street food production in Florianopolis, Brazil: A cross-sectional study. Food control. 2016 Apr 1;62:178–86.
27. Zwe YH, Yuk HG. Food quality and safety in Singapore: microbiology aspects. Food Qual Saf. 2017 May 1;1(2):101–5.
28. Seow J, Ágoston R, Phua L, Yuk HG. Microbiological quality of fresh vegetables and fruits sold in Singapore. Food control. 2012 May 1;25(1):39–44.
29. Kechero FK, Baye K, Tefera AT, Tessema TS. Bacteriological quality of commonly consumed fruit juices and vegetable salads sold in some fruit juice houses in Addis Ababa, Ethiopia. J Food Saf. 2019 Feb;39(1):e12563.
30. Mohamed MY, Habib I. Pathogenic E. coli in the food chain across the Arab countries: a descriptive review. Foods. 2023 Oct 11;12(20):3726.
31. Agustín MD, Brugnoni L. Multispecies biofilms between Listeria monocytogenes and Listeria innocua with resident microbiota isolated from apple juice processing equipment. J Food Saf 2018 Oct;38(5):e12499.
